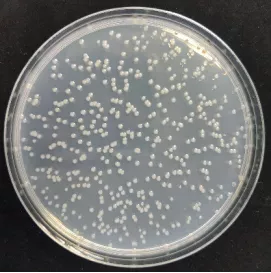

【摘要】 在微生物相关的实验中,大肠杆菌是最常用的菌株。
在微生物相关的实验中,大肠杆菌是最常用的菌株。

大肠杆菌电镜图像
关于大肠杆菌浓度的测定以及计算有许多方法。今天就给大家介绍以分光光度计以及荧光光度计连续监测的方法,通过检测培养液吸光强度和荧光强度随时间的变化并建立微生物生长曲线,确定吸光强度和荧光强度检测阈值。
大肠杆菌菌落
据此测定达到阈值吸光强度和荧光强度所需时间,推导并验证了检测时间与菌初始浓度之间的线性关系,建立阈值检测曲线。

大肠杆菌菌液浓度曲线图
利用定时培养检测方法建立定时检测曲线。采用上述两种定量方法所有微生物检测约10h可完成。

1、将菌种接种于斜面培养24 h,用接种环挑取菌体于无菌水中,然后依次稀释10倍制备一系列浓度梯度的菌悬液,并用97孔定量盘检测其浓度。
2、确定检测波长在无菌的试剂中加入大肠杆菌后37℃培养12 h,以无菌的试剂为空白,用紫外分光光度计对其进行全波长扫描以确定其最佳检测波长。在激发光为365 nm条件下,用荧光光度计进行全波长扫描以确定荧光物质的最佳检测波长。
3、确定检测國值用无菌水将培养试剂溶解,制备两倍浓度的培养试剂。将等体积的两倍浓度试剂和菌悬液混合后密封,37℃培养。每隔20 min检测吸光强度和荧光强度变化,根据过程变化确定检测阈值。
4、定时培养方式2-3 mL体系在比色皿封闭体系中或无色透明5 mL玻璃瓶中培养,每隔一定时间检测培养体系中410 nm处及365 nm激发光所激发荧光变化。此种培养方式便于无菌培养、连续检测或定时检测,不需要连续取样。过程简单、操作方便。

此方法通过检测和观察微生物生长过程中的变化,可确定吸光强度(△A=0.1)和荧光强度(△F=0.1)检测阈值。经过数学推导和实验验证,建立大肠杆菌初始浓度与阈值检测时间之间的线性关系。利用此曲线方程,只需记录阈值所需的检测时间即可推算出水中微生物的初始浓度,计算过程十分简单。

关于大肠杆菌等常用菌类的浓度检测方法数不胜数,检测方法也会越来越简单和科学。
如需获得更多生物医学干货及预约测试可联系:科学指南针 小宁师弟(+V:lhn988220)!





您已经拒绝加入团体

